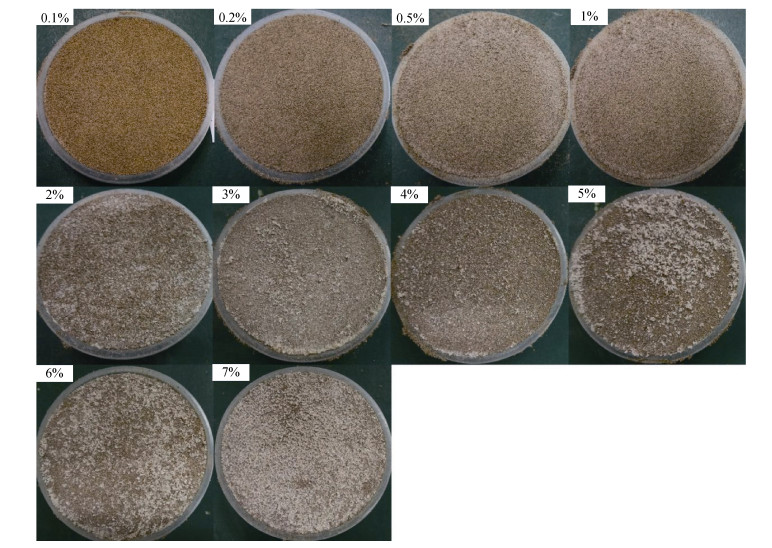

2. 新疆大学资源与环境科学学院, 乌鲁木齐 830046;
3. 新疆大学绿洲生态教育部重点实验室, 乌鲁木齐 830046
在干旱、半干旱区的土壤表层或内部,盐晶体常胶结土壤颗粒形成盐结皮(即“盐壳”,salt crust)[1]。盐结皮的形成能够显著增强表层土壤强度,抑制水分蒸发,减少地表粉尘释放,提高土壤抗风蚀性能。盐结皮在干旱区生态环境中具有十分重要的作用,盐结皮研究逐步引起科研工作者的关注。
NaCl是自然界分布广泛且含量较大的一种盐。NaCl盐结皮在自然界中较为常见,常分布于干旱区洼地、河流尾闾和盐湖边缘。广大学者对于NaCl盐结皮的结皮形态、抗风蚀性能以及对水蒸发的影响进行了大量研究[2-8]。常温下,NaCl在土壤或多孔介质中常形成表面盐结皮[9-11],表面形态有“壳”状(crusty)和“补丁”状(patchy)[12]。Eloukabi等[10]在NaCl结皮表观形态形成的试验中发现,粒径5~160 μm时,形成了“壳”状(crusty),而粒径200~300 μm时,形成“补丁”状(patchy)。NaCl结皮在自然环境下能够明显改善土壤的抗风蚀性能[13-16]。Bauer等[17]在风洞研究NaCl与KCl结皮抗风蚀性,发现含有NaCl结皮能够显著增大风沙土的起风阈值,减少表面射出的颗粒流。NaCl结皮对土壤水分蒸发产生严重影响[18-22]。Fujimaki等[18]发现NaCl盐结皮对水分蒸发有明显的抑制作用,李诚志和刘志辉[19]在塔里木河下游通过对比有无盐结皮土壤水分,发现含有NaCl结皮的土壤明显比无盐结皮的土壤水分含量高。
盐结皮能够增强土壤的抗风蚀性,可以通过其强度与韧性来体现[23-24]。Rad等[25]在研究不同粒径的砂石与盐胶结时,发现形成的结皮越厚、结构强度越强的样品,其在风洞试验环境下的表现越好,抗风蚀能力越优;Langston和Mckenna[24]在对比生物结皮与盐结皮的抗风蚀性能时,指出除了结皮强度、保水能力之外,结皮的韧性也是影响土壤抗风蚀性能的一个重要影响因素,研究表明,结皮的韧性越强,抗风蚀性能越佳。虽然NaCl盐结皮在很多方面研究已取得了长足的进展,但NaCl含量变化对盐结皮的抗风蚀性能有多大影响?这个问题一直还悬而未决。本文以风沙土作为试验土壤,通过设置不同NaCl浓度来形成盐结皮,测定各浓度盐结皮的表面形态、抗压强度和韧性,探索NaCl浓度对盐结皮抗风蚀性能的影响。研究结果为沙漠治理、生态修复等工程应用提供理论指导。
1 材料与方法 1.1 试验区概况本试验风沙土取自于新疆塔里木盆地东部若羌县北面的流动沙漠,即塔克拉玛干沙漠的东部边缘。塔克拉玛干沙漠面积约为33.5万km2,平均海拔1 200 m,年平均降水量从盆地西部的40 mm逐渐递减到东部的5 mm。本研究区年降雨量小于10 mm,潜在蒸发量达2 500~3 400 mm;受西风带偏转的影响,该地区常年盛行东北风,平均风速约为6.8 m/s,一年风沙日超过100 d,地表形成高度为10~150 m的沙丘。该地区沙土中含有大量的盐(以NaCl为主,含有Na2SO4、Na2CO3、KCl、K2CO3等),在台特玛湖附近有大量的自然盐结皮存在。
1.2 试验材料试验风沙土来自于塔克拉玛干沙漠东部流动沙丘,主要粒径分布在100~200 μm(约占总体积质量的72.2%)[26]。采集的自然风沙土中含有NaCl、Na2SO4、Na2CO3等可溶性盐,为了降低自然风沙土中可溶性盐对试验的影响,对采集的风沙土进行去盐处理。用去离子水浸泡风沙土24 h,然后移除上清液,再加去离子水,直至浸泡液体的电导率小于1.0×10–2 S/m(自来水电导率)时停止清洗。将去盐后的风沙土放置于烘箱内烘干,然后用3D震动筛(ZSY-1000)对风沙土进行筛分。为避免粒径不同而对NaCl盐结皮产生影响,本研究选择粒径占比最大的组分,即100~200 μm的沙子进行试验。NaCl选择纯度为99.99% 的实验研究级别的NaCl盐,去离子水为溶剂。
1.3 试验方案前期试验时显示含盐量低(一般小于10%)时,结皮特征变化相对明显,而含盐量大于10% 后变化不明显[26],故本文设置NaCl含盐量梯度为0.1%、0.2%、0.5%、1.0%、2.0%、3.0%、4.0%、5.0%、6.0% 和7.0%(盐占混合物的百分比)。将盐与粒径为100~200 μm的风沙土混合,然后搅拌均匀加入去离子水,再次搅拌制成试验样品,将每一个梯度设置10个重复样,形成100个样品。然后用100个规格相同的耐热塑料杯盛放样品,再将塑料杯放入恒温烘干箱内,温度设定为75 ℃,持续烘干24 h后取出,使用高清数码相机拍样品形成的盐结皮,观测样品的外观颜色以及表层特性,记录结皮变化情况,进行结皮抗压试验。
1.4 盐结皮抗压强度测定NaCl盐结皮抗压强度测试,仪器选用HP-1000N数字式电子压力计(量程为1000N,分度值为0.1N,误差为±0.2N)。将已经获得的盐结皮样本放入HSV- 500立式电动工作台,探针测试速度设定为1 mm/s。压力计与计算机连接,自动记录应力-时间关系曲线及压力数据,以曲线的最大峰值作为强度值,而达到最大峰值所需时间表示盐结皮的抗压韧性。
1.5 数据分析对抗压强度和应力-时间数据进行处理,通过计算每一组样本的抗压强度均值与方差,采用SigmaPlot 12.0等软件对数据进行线性拟合与方差分析。由于结皮的抗压强度以及韧性能够很大程度上反映其抗风蚀性能,因此通过分析NaCl盐结皮的抗压强度特性以及韧性特性来明确风沙土最佳抗风蚀性能时的含盐量。
2 结果 2.1 不同NaCl含盐量的结皮表面特征随着土壤含盐量不断增大,NaCl盐结皮的表面呈现规则性的纹理特征(图 1)。
|
图 1 不同NaCl含量的风沙样土结皮表面 Fig. 1 Salt crust images of aeolian sandy soil with different NaCl contents |
随着土壤含盐量的不断增大,样品表面由沙土的红褐色变成红棕色,再逐渐变成灰白色,最终呈现出白色。当含盐量在0.1%~0.2% 时,颜色为风沙土样的红褐色;当含盐量为0.5%~1.0% 时,表面开始出现少量的、细小的灰白色NaCl结晶颗粒;当含盐量为2.0%~6.0% 时,土样表面的灰白色细小盐颗粒形成了大颗粒且不规则集聚的盐斑,随着含盐量的升高,盐斑的面积也随之增大;当含盐量达到7.0% 时,土样的表面大部分被盐斑覆盖。结皮纹理呈现出规律性变化,表面粗糙度也随含盐量不断提高。含盐量为1.0% 以下时,沙土表面细密平整;2.0% 时出现突出的细小盐斑突起,随着含盐量的增大,这种盐斑突起越来越密集,并逐步过渡到疏松多孔的盐层。
2.2 不同NaCl含盐量的结皮抗压强度特性不同NaCl含量的风沙土样形成的盐结皮抗压强度如图 2所示,随着含盐量的增加,盐结皮的抗压强度呈现出先上升后下降再上升的规律。NaCl含盐量小于1.0% 时,盐结皮抗压强度随着含盐量的增加而缓慢增加;NaCl含盐量1.0%~4.0% 时,抗压强度随着含盐量的增加而迅速增加;含盐量4.0% 时,结皮强度达峰值,为375 N/cm2,之后出现一个明显的波动状态;在含盐量为5.0% 时,强度出现第一个明显的跌落点,其峰值为249 N/cm2,相对于含盐量为4.0% 的峰值而言跌落126 N/cm2;含盐量为6.0% 时又出现上升趋势,然而7.0% 又出现一个回落。总体来看,抗压强度随着含盐量的增加而增加。强度的方差值随着强度的增加呈现增大趋势,在含盐量小于3.0% 时,强度的方差较小,均小于64.51;含盐量大于3% 后,强度的方差增大,方差最大值出现在含盐量为5.0% 时,达到72.84。可见,强度越高其离散程度较高,抗压强度一致性越差。

|
图 2 NaCl含量对结皮抗压强度的影响 Fig. 2 Effect of NaCl content on compressive strength of salt crust |
试验使用HP-1000N数字式电子压力测试机(自带计算机绘图软件,量程为1000N,精度为0.1N)记录结皮破坏时的应力变化过程,其抗压曲线如图 3所示。应力-时间曲线达到峰值的斜率能反映结皮的韧性,大小可以用弹性模量来表征。弹性模量越大结皮韧性越小,结皮破碎时形变越小,结皮越脆,抗压强相同时结皮抗侵蚀打击次数就越少;相反弹性模量越小结皮的韧性越大,结皮的延展性越好,抗压强度相同时结皮的抗侵蚀打击次数也越多。

|
图 3 不同NaCl含量的结皮应力变化曲线 Fig. 3 Stress curves of salt crusts with different NaCl contents |
从图 3可知,随着NaCl含盐量的增加,结皮达最大抗压强度,而破坏的时间则呈现先增加后减少的趋势。在含盐量小于3.0% 时,破坏时间随着含盐量的增大而增加,曲线斜率(抗压强度与时间的比值,表示结皮的韧性)则逐渐递减,韧性逐步增大。含盐量为3% 时,时间达最大,约为53 ms,曲线斜率也很小,其弹性模量为73 kPa,结皮的韧性最大。当含盐量大于3.0% 时,破坏时间随着含盐量的增大而减小,此时曲线斜率数值由6.77一直单调递增到24.46;含盐量7% 时,结皮的弹性模量达到最大值233 kPa,但是却只用13 ms,盐结皮韧性最小。曲线斜率能够很好地反映结皮的韧性,斜率越小则韧性越好,反之斜率越大则脆性越强。从抗风蚀角度看,结皮韧性越好,表示其抗蚀时间越长,相反则抗蚀时间短。
3 讨论 3.1 NaCl含量对盐结皮抗压强度的影响从图 1可以明显看出随着含盐量的增加,风沙土的表观物理特性发生了明显改变。随着含盐量的增大,表面盐聚集越多,表面也逐步过渡到疏松多孔的盐层。但NaCl盐结皮的抗压强度随着含盐量增加出现先增后降再增加的情况。出现这种情况可能与盐结皮的微观结构变化有关。Shokri-kuehni等[27]的研究表明NaCl含盐量和结晶温度会影响晶体内部孔隙度,进而影响盐结皮的数量和结构形态。结皮过程中,不同的含盐量和温度会导致结皮特性不同。本试验在75 ℃恒温条件下完成,结皮盐晶体都是无水NaCl结晶体,可以排除温度的影响,所以造成盐结皮强度变化的原因可能是由含盐量不同。为了探明NaCl含量具体对盐结皮抗压强度的影响,需要对结皮进行微观研究。故本文用立体显微镜在500倍的情况下对样品表面进行观察,盐结皮放大图如图 4所示。当NaCl含盐量在0.1%~1.0% 时,表面的胶结程度不明显,仅在个别颗粒表面出现盐晶体,盐结皮表面整体性较差;当含盐量从2.0% 增加到4.0% 时,表面盐晶体迅速增加,表面颗粒逐步被胶结在一起。风沙土表面孔隙逐步被盐结晶颗粒填充。初期形成的盐结晶颗粒不足以填满所有的孔隙,随着含盐量的增大,NaCl结晶体的数量不断增加,盐颗粒与土颗粒的胶结程度也逐渐增强,其外在表现形式为表层形成盐壳,内在形式为抗压强度增加。当NaCl含量达4.0% 时,表层孔隙几乎被盐结晶填充满,表面形成致密盐壳,抗压强度达到最大值。当含盐量达到5.0% 时,盐结皮表面出现大量不规则的聚集盐晶体,结皮局部厚度增加,这种不均匀性导致结皮强度方差增大;同时在表观形态上出现表面疏松盐晶体,这可能导致结皮强度下降。随着盐含量的继续增加,表面盐晶体继续增加,结皮厚度增加,不均匀性相对减少,抗压强度有所提升;表观形态上虽然出现表面疏松盐晶体,但这疏松盐晶体导致的结皮强度下降小于结皮厚度增加造成的结皮强度增加,整体上显示抗压强度上升。最近的研究也表明,NaCl在盐结皮的形成过程中并不是均匀分布的,而是呈现出“树突”状晶体分布[28-30]。盐含量的增加还会导致盐晶体在表层下部的孔隙中结晶,增加盐晶体分布的复杂性,导致盐结皮抗压强度复杂变化。

|
图 4 不同NaCl含量的盐结皮显微镜图(500倍) Fig. 4 Microscopic images of salt crusts with different NaCl contents (magnified 500 times) |
NaCl结皮韧性与结皮强度之间存在一定的联系,但又存在差别。在含盐量小于3.0% 时,NaCl结皮的韧性和强度都随着含盐量的增加而增大。含盐量大于3.0% 后,两者存在明显区别。结皮强度出现先增后降再增加的现象,结皮强度最大值出现在含盐量4.0%;结皮韧性则随着含盐量的增加而下降。出现这种现象的原因可能是NaCl晶体的韧性与风沙土颗粒胶结形成的盐结皮韧性存在较大差异。NaCl晶体在地层中存在,叫做石盐或岩盐,是一种脆性材料,弹性模数(应力-应变曲线中,直线段的斜率)在12×103~15×103 MPa[31]。本文中NaCl结皮的弹性模量最大才233 kPa,比岩盐少了9个数量级。随着盐结皮的盐晶体厚度增加,盐结皮的韧性就可能会越接近岩盐,其弹性模量就会逐步增大。这点在2.3部分中得到验证,当含盐量大于3.0% 后,盐结皮的弹性模量随着含盐量的增加越来越大,结皮韧性逐步向岩盐靠近,越来越向脆性发展。在含盐量小于3% 时,盐晶体与土壤颗粒逐步胶结形成一个整体,盐结皮的弹性模量随着含盐量增加逐步减小,但是弹性模量的减小幅度很小,整体仍呈脆性。当然,在含盐量小于3% 时,为什么盐结皮韧性会增加?这现象的具体机理还需进一步研究。
3.3 NaCl盐结皮对土壤抗风蚀性能的影响前人研究显示盐结皮可以有效地阻止表层风沙土流动,保护下部松散土壤,减少土壤风蚀。NaCl将土壤表层原本疏松的土壤颗粒胶结在一起,这种胶结作用显著地提升了土壤的风蚀起动阈值[17],起动风速大小与结皮的强度以及韧性也有着很强的关系[14, 32],盐结皮中的盐晶体将分散的土壤颗粒胶结成大土壤颗粒或将土壤胶结为整体。大土壤颗粒或团块体增大了土壤风蚀起动风速阈值[14],当胶结块形成一个整体,则土壤的强度与韧性就会大大提升,能够显著增强土壤的抗风蚀能力。Argaman等[33]研究显示土壤盐结皮能够将起动风速阈值提升1~2个数量级。盐浓度和结皮厚度对土壤盐结皮的抗风蚀性有较大影响。O’Brien和Mckenna[34]研究显示盐溶液浓度低时,土壤表面未出现完整盐结皮,表面颗粒流依然很大;当达到一定浓度时,表面盐结皮形成,表面颗粒流急剧下降。Nield等[35]在对不同厚度壳状盐结皮进行风洞试验时,也发现厚壳状盐结皮比薄壳状盐结皮有着更高的起动风速阈值。
本试验的NaCl风沙土结皮试验也显示NaCl盐结皮能够增加土壤表层强度,抑制尘土飞扬,增强土壤的抗风蚀性,但NaCl含量对结皮的抗风蚀性具有显著影响。NaCl含量在0~4.0% 时,随着NaCl含量增加,盐结皮的抗压强度单调递增;NaCl含量大于4.0% 时,盐结皮抗压强度反而出现了跌落。NaCl含量在0~3.0% 时,盐结皮的韧性也随NaCl含量增加呈单调递增;NaCl含量大于3.0% 时,韧性逐步减小。从抗风蚀性角度看,盐结皮存在着最适盐含量。本研究的试验结果显示,4.0% 含盐量时结皮抗压强度最高,达400 N/cm2;3.0% NaCl含盐量时结皮韧性最好,抗破坏时长达53 ms。然而,3.0% 含盐量时的盐结皮抗压强度仅比4.0% 时小10 N/cm2。综合考虑盐结皮的抗压强度和韧性,NaCl含量3.0% 时形成的盐结皮抗风蚀最强。
4 结论1) NaCl结皮的强度随着含盐量的增加呈先上升后下降的趋势,含盐量为4.0% 时抗压强度达到峰值。
2) 结皮韧性随着含盐量的增加先上升后下降。NaCl含盐量为3.0% 时,到达峰值所需时间长达53 ms。
3) 从土壤抗风蚀性角度看,NaCl含盐量3.0% 时盐结皮的抗压强度接近最大强度,结皮韧性最大,NaCl风沙土盐结皮最优,抗风蚀性能最好。
4) NaCl晶体聚集状态对盐结皮抗风蚀性能产生影响。盐含量大于4% 时,结皮盐晶体出现盐斑聚集,这种聚集会改变结皮抗压强度,导致结皮抗压强度复杂变化。
| [1] |
Christiansen F W. Polygonal fracture and fold systems in the salt crust, great salt lake desert, Utah[J]. Science (New York, N Y), 1963, 139(3555): 607-609 DOI:10.1126/science.139.3555.607 (  0) 0) |
| [2] |
Shokri-Kuehni S M S, Raaijmakers B, Kurz T, et al. Water table depth and soil salinization: From pore-scale processes to field-scale responses[J]. Water Resources Research, 2020, 56(2): 599-609 (  0) 0) |
| [3] |
Qazi M J, Bonn D, Shahidzadeh N. Drying of salt solutions from porous media: Effect of surfactants[J]. Transport in Porous Media, 2019, 128(3): 881-894 DOI:10.1007/s11242-018-1164-5 (  0) 0) |
| [4] |
刘广明, 杨劲松. 地下水作用条件下土壤积盐规律研究[J]. 土壤学报, 2003, 40(1): 65-69 DOI:10.3321/j.issn:0564-3929.2003.01.009 (  0) 0) |
| [5] |
陈永宝, 胡顺军, 罗毅, 等. 新疆喀什地下水浅埋区弃荒地表层土壤积盐与地下水的关系[J]. 土壤学报, 2014, 51(1): 75-81 (  0) 0) |
| [6] |
邹平, 杨劲松, 福原辉幸, 等. 蒸发条件下土壤水盐热运移的实验研究[J]. 土壤, 2007, 39(4): 614-620 DOI:10.3321/j.issn:0253-9829.2007.04.022 (  0) 0) |
| [7] |
Johnson E, Yáñez J, Ortiz C, et al. Evaporation from shallow groundwater in closed basins in the Chilean Altiplano[J]. Hydrological Sciences Journal, 2010, 55(4): 624-635 DOI:10.1080/02626661003780458 (  0) 0) |
| [8] |
Nachshon U, Weisbrod N, Dragila M I, et al. Combined evaporation and salt precipitation in homogeneous and heterogeneous porous media[J]. Water Resources Research, 2011, 47(3): 980-990 (  0) 0) |
| [9] |
Sghaier N, Prat M. Effect of efflorescence formation on drying kinetics of porous media[J]. Transport in Porous Media, 2009, 80(3): 441-454 DOI:10.1007/s11242-009-9373-6 (  0) 0) |
| [10] |
Eloukabi H, Sghaier N, Ben Nasrallah S, et al. Experimental study of the effect of sodium chloride on drying of porous media: The crusty-patchy efflorescence transition[J]. International Journal of Heat and Mass Transfer, 2013, 56(1/2): 80-93 (  0) 0) |
| [11] |
Naillon A, Duru P, Marcoux M, et al. Evaporation with sodium chloride crystallization in a capillary tube[J]. Journal of Crystal Growth, 2015, 422: 52-61 DOI:10.1016/j.jcrysgro.2015.04.010 (  0) 0) |
| [12] |
Norouzi Rad M, Shokri N. Effects of grain angularity on NaCl precipitation in porous media during evaporation[J]. Water Resources Research, 2014, 50(11): 9020-9030 DOI:10.1002/2014WR016125 (  0) 0) |
| [13] |
Nield J M, Wiggs G F S, King J, et al. Climate-surface-pore-water interactions on a salt crusted playa: Implications for crust pattern and surface roughness development measured using terrestrial laser scanning[J]. Earth Surface Processes and Landforms, 2016, 41(6): 738-753 DOI:10.1002/esp.3860 (  0) 0) |
| [14] |
Rice M A, McEwan I K. Crust strength: A wind tunnel study of the effect of impact by saltating particles on cohesive soil surfaces[J]. Earth Surface Processes and Landforms, 2001, 26(7): 721-733 DOI:10.1002/esp.217 (  0) 0) |
| [15] |
Fryrear D W. Mechanics measurement and modeling of wind erosion[J]. Advances in GeoEcology, 1998, 31: 291-300 (  0) 0) |
| [16] |
张建国, 徐新文, 雷加强, 等. 极端干旱区咸水滴灌林地盐结皮对土壤蒸发的影响[J]. 农业工程学报, 2010, 26(9): 34-39 DOI:10.3969/j.issn.1002-6819.2010.09.006 (  0) 0) |
| [17] |
Bauer B O, Houser C A, Nickling W G. Analysis of velocity profile measurements from wind-tunnel experiments with saltation[J]. Geomorphology, 2004, 59(1/2/3/4): 81-98 (  0) 0) |
| [18] |
Fujimaki H, Shimano T, Inoue M, et al. Effect of a salt crust on evaporation from a bare saline soil[J]. Vadose Zone Journal, 2006, 5(4): 1246-1256 DOI:10.2136/vzj2005.0144 (  0) 0) |
| [19] |
李诚志, 刘志辉. 塔里木河下游土壤风蚀期0-15 cm层土壤含水率分布规律[J]. 地理科学, 2012, 32(4): 511-515 (  0) 0) |
| [20] |
李红寿, 汪万福, 武发思, 等. 盐分对极干旱土壤水分垂直分布与运转的影响[J]. 土壤, 2011, 43(5): 809-816 (  0) 0) |
| [21] |
Dai S, Shin H, Santamarina J C. Formation and development of salt crusts on soil surfaces[J]. Acta Geotechnica, 2016, 11(5): 1103-1109 DOI:10.1007/s11440-015-0421-9 (  0) 0) |
| [22] |
Nachshon U, Weisbrod N. Beyond the salt crust: On combined evaporation and subflorescent salt precipitation in porous media[J]. Transport in Porous Media, 2015, 110(2): 295-310 DOI:10.1007/s11242-015-0514-9 (  0) 0) |
| [23] |
Bergstad M, Shokri N. Evaporation of NaCl solution from porous media with mixed wettability[J]. Geophysical Research Letters, 2016, 43(9): 4426-4432 DOI:10.1002/2016GL068665 (  0) 0) |
| [24] |
Langston G, McKenna N C. An experimental study on the susceptibility of crusted surfaces to wind erosion: A comparison of the strength properties of biotic and salt crusts[J]. Geomorphology, 2005, 72(1/2/3/4): 40-53 (  0) 0) |
| [25] |
Rad M N, Shokri N, Keshmiri A, et al. Effects of grain and pore size on salt precipitation during evaporation from porous media[J]. Transport in Porous Media, 2015, 110(2): 281-294 DOI:10.1007/s11242-015-0515-8 (  0) 0) |
| [26] |
王大环, 李诚志, 李沼鹈. Na2SO4对古尔班通古特沙漠细沙盐结皮特性的影响[J]. 环境科学研究, 2018, 31(11): 1979-1986 (  0) 0) |
| [27] |
Shokri-Kuehni S M S, Norouzi Rad M, Webb C, et al. Impact of type of salt and ambient conditions on saline water evaporation from porous media[J]. Advances in Water Resources, 2017, 105: 154-161 DOI:10.1016/j.advwatres.2017.05.004 (  0) 0) |
| [28] |
Hird R, Bolton M D. Migration of sodium chloride in dry porous materials[J]. Proceedings of the Royal Society A: Mathematical, Physical and Engineering Sciences, 2016, 472(2186): 20150710 DOI:10.1098/rspa.2015.0710 (  0) 0) |
| [29] |
Derluyn H, Vontobel P, Mannes D, et al. Saline water evaporation and crystallization-induced deformations in building stone: Insights from high-resolution neutron radiography[J]. Transport in Porous Media, 2019, 128(3): 895-913 DOI:10.1007/s11242-018-1151-x (  0) 0) |
| [30] |
Desarnaud J, Derluyn H, Carmeliet J, et al. Hopper growth of salt crystals[J]. The Journal of Physical Chemistry Letters, 2018, 9(11): 2961-2966 DOI:10.1021/acs.jpclett.8b01082 (  0) 0) |
| [31] |
工程地质手册编委. 工程地质手册[M].
中国建筑工业出版社, 北京, 1993: 784-789
(  0) 0) |
| [32] |
Goossens D. Effect of soil crusting on the emission and transport of wind-eroded sediment: Field measurements on loamy sandy soil[J]. Geomorphology, 2004, 58(1/2/3/4): 145-160 (  0) 0) |
| [33] |
Argaman E, Singer A, Tsoar H. Erodibility of some crust forming soils/sediments from the Southern Aral Sea Basin as determined in a wind tunnel[J]. Earth Surface Processes and Landforms, 2006, 31(1): 47-63 DOI:10.1002/esp.1230 (  0) 0) |
| [34] |
O'Brien P, McKenna Neuman C. A wind tunnel study of particle kinematics during crust rupture and erosion[J]. Geomorphology, 2012, 173(173/174): 149-160 (  0) 0) |
| [35] |
Nield J M, McKenna Neuman C, O'Brien P, et al. Evaporative sodium salt crust development and its wind tunnel derived transport dynamics under variable climatic conditions[J]. Aeolian Research, 2016, 23: 51-62 DOI:10.1016/j.aeolia.2016.09.003 (  0) 0) |
2. College of Resources and Environmental Sciences, Xinjiang University, Urumqi 830046, China;
3. Key Laboratory of Oasis Ecology, Ministry of Education, Xinjiang University, Urumqi 830046, China
 2021, Vol. 53
2021, Vol. 53


